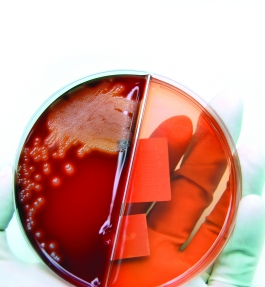

QP Module 4: Pharmaceutical Microbiology
Print
Qualified Person and Professional Development Training - Module 4
Dates:
Monday 28 April to Friday 02 May 2025
Venue:
Amsterdam Marriott Hotel, Amsterdam, The Netherlands
Cost:
£3200.00 excl. VAT or £3840.00 incl. VAT
(2nd delegate bookings from the same company and same site will receive a 20% discount on the course fee)
Type: Pharmaceutical
About this course
Microbiological contamination of products and processes continues to be a major concern to the industry and its regulators. The potential impact of such contamination can be catastrophic. Put simply, microbial contamination can kill your patients and your business! This course, for non-biologists and microbiologists, is designed to provide you with the knowledge, confidence and decision making risk assessment skills to prevent this happening. You will learn:
- The basic characteristics of all microorganisms found in your pharmaceutical environment, how they get there and how you can remove them
- How you can sample, isolate, count and identify these microorganisms
- How to prevent contamination of your products and processes using practical risk management and risk assessment tools and techniques
- How to interpret microbiological data in order to make the right ‘risk-based’ decisions – decisions that will satisfy the regulators, protect your patient and improve your operational efficiency
Why This Training Will Benefit YOU
The Aspiring Qualified Person
- This series of 12 modules held over a 21 month period has been carefully designed to meet the requirements for theoretical training detailed in the latest UK Qualified Person Study Guide and EC Directives 2001/82/EC and 2001/83/EC.
- All our training courses provide practical, face-to-face tuition in sufficient depth to prepare you fully for the challenges that lie ahead.
- Our training is generally considered as the best available and our QPs are held in high regard within the industry.
- As well as being accepted in the UK, our training courses are well known and accepted by several other EU countries, including Ireland, The Netherlands, Austria, Hungary and Malta.
- You are more likely to become a QP with us than with any other training provider!
The Pharmaceutical Technical Professional
- Not all the people attending these courses intend to become QPs. Many use the training to develop as technical managers within other areas of pharmaceutical manufacture and control.
- Increasingly, companies are using these modules as part of a modular technical and professional development plan for their staff.
- Additionally, many industry professionals attend the courses as part of their Continuing Professional Development.
- This course is designed to lead to Postgraduate Certificate, Diploma and MSc qualifications depending on modules taken and work commitment by students. For further details, please contact Stella Pearson-Smith, our QP Course Administrator at [email protected] for more information.
Course outline
Microorganisms: Understanding your ‘Enemy’!
- The physiology and key characteristics of microorganisms
- Routes of contamination: How they get from their ‘source’ into your product
Microbiological Methods: ‘How to’ Guidance on…
- Methods of sampling
- Isolation and enumeration (counting)
- Methods of identification: How and when to identify microorganisms
- A review of key test methods including the test for sterility and preservative efficacy
- The use of Process Analytical Technology (PAT)
- Rapid (non-culturable) methods
- The microbiology laboratory: What are ‘Good Laboratory Practices’?
- Monitoring methods: How to establish a sensitive and cost-effective monitoring programme
Microorganisms and your Products, Procedures and Plants
- Raw materials: The microbiological risk assessment and testing of raw materials and non-sterile products. Who must do what, when and how
- Contamination control strategies: How to prevent contamination of your product and plant
- Microbiological aspects of good plant and process design (sterile and non-sterile)
- How to use media fills to assess the vulnerability of your process to contamination
- How to use risk assessment and hazard analysis to identify and remove contamination risks
Microorganisms: How to Remove Them!
- Good sanitisation practices
- The kinetics of sterilisation
- Sterilisation: The principles, practice and validation of:
- Moist heat
- Filtration
- Dry heat
- Other methods
- Antibiotics: How they work and how you test them
Decision Making and Problem Solving
- How to interpret microbiological data and trends
- How to identify the root cause of contamination incidents
- How to use risk assessment techniques to assess the impact of ‘failures’ on product quality and patient safety
Discussion and Working Groups
A significant proportion of the course time will be devoted to group work, where delegates have the opportunity, through case studies, to put theory into practice.
Additionally, discussion periods, including a course tutor panel session, provide delegates with an opportunity to obtain answers to their specific questions and concerns.
Elements of the course will be run as practical experiments and demonstrations.
Venue
Amsterdam Marriott Hotel, Amsterdam, The Netherlands
The Amsterdam Marriott Hotel is among the superior hotels in Amsterdam, it offers an ideal location across from the Leidseplein’s fine shopping, dining and entertainment.
As a guest, you’ll find well appointed guest rooms with high speed internet to keep you in touch. A well equipped fitness room will help keep you in shape. Fine dining awaits in their two restaurants.
Hotel Accommodation
- Online early booking offer – we have negotiated a discounted bed and breakfast rate including free wi-fi.
- To take advantage of this offer, you must book via a special weblink, details of which will be provided to you on receipt of a completed booking form.
- This offer is only available until four weeks before the course start date, after which point the hotel cannot guarantee room or rate availability.
- If you need any help or guidance with the accommodation booking process, please contact our course administration team.
- Your account with the hotel should be settled at check-out.
- Any charges made by the hotel as a result of you not taking up your reservation for any reason will remain your responsibility, therefore please ensure you are aware of the hotel’s cancellation policy.
Venue Address and Contact Details
Amsterdam Marriott Hotel
Stadhouderskade 12
Amsterdam, 1054 ES
The Netherlands
Tel: +31 20 607 5555
Fax: +31 20 607 5511
www.marriott.com
Hotel Bookings
If you would like to benefit from our specially negotiated Bed and Breakfast rate with the hotel, please book your accommodation following “this link - link to be confirmed shortly”
This offer is only available until four weeks before the course start date, after which point the hotel cannot guarantee room or rate availability.
Tutors
We believe that our team of experts are the best available. Not only have they got years of experience in the industry, but they are committed to tutoring and helping those inside the industry to improve and raise the standards. We understand that you attend courses to learn about the latest regulations and to get your questions answered.
Our experts for this course are:
- Gavin Halbert, University of Strathclyde, UK
What you've said
“Really interesting. Very enjoyable. Answered all my questions”
Neil Housley, Nova Laboratories, UK
“For me it has been a great learning week, with amazing atmosphere and very deep group discussions”
Javier Castañeira, MSD Animal Health, Spain
“ Very helpful in realization of the significant role micro can play in manufacturing processes and not just at the final product and environmental monitoring areas”
Bertie Craig, Newcastle University
“The buzz groups have been invaluable. Sharing experiences with other delegates has been useful. The course has given me the understanding of pharmaceutical microbiology that will allow me to understand the risks to the patient, products and processes, etc”
David Franks, Reckitt Benckiser
“I came on this course with minimal knowledge and so I was looking forward to this course to give me a flavor of microbiology. The course more than met my expectations. Thank you very much”
Adam Haigh, Perrigo